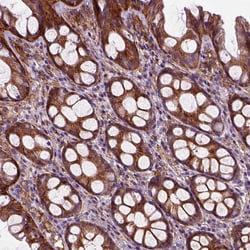
Invitrogen MARCKS Polyclonal Antibody 100 &mu;L; Unconjugated:Antibodies,

missing translation for 'onlineSavingsMsg'
Learn More
Learn More
Invitrogen™ MARCKS Polyclonal Antibody


Rabbit Polyclonal Antibody
Brand: Invitrogen™ PA584812
This item is not returnable.
View return policy
Description
Immunogen sequence: MGAQFSKTAA KGEAAAERPG EAAVASSPSK ANGQ Highest antigen sequence indentity to the following orthologs: Mouse - 97%, Rat - 100%.
MARCKS is a substrate for protein kinase C. It is localized to the plasma membrane and is an actin filament crosslinking protein. Phosphorylation by protein kinase C or binding to calcium-calmodulin inhibits its association with actin and with the plasma membrane, leading to its presence in the cytoplasm. The protein is thought to be involved in cell motility, phagocytosis, membrane trafficking and mitogenesis.
Specifications
| MARCKS | |
| Polyclonal | |
| Unconjugated | |
| MARCKS | |
| 80K protein; 80K-L; 80K-L protein; FLJ14368; FLJ90045; KINC; Macs; MARCKS; MARCS; myristoylated alanine rich protein kinase C substrate; myristoylated alanine-rich C-kinase substrate; Myristoylated alanine-rich protein kinase C substrate; myristoylated alanine-rich protein kinase C substrate (MARCKS, 80K-L); phosphomyristin; PKCSL; PRKCSL; protein kinase C substrate 80 kDa protein; protein kinase C substrate, 80 kDa protein, light chain | |
| Rabbit | |
| Antigen affinity chromatography | |
| RUO | |
| 4082 | |
| Store at 4°C short term. For long term storage, store at -20°C, avoiding freeze/thaw cycles. | |
| Liquid |
| Immunohistochemistry (Paraffin), Western Blot | |
| 0.1 mg/mL | |
| PBS with 40% glycerol and 0.02% sodium azide; pH 7.2 | |
| P29966 | |
| MARCKS | |
| Recombinant protein fragment of Human MARCKS (Product #RP-106576) | |
| 100 μL | |
| Primary | |
| Human | |
| Antibody | |
| IgG |
Product Content Correction
Your input is important to us. Please complete this form to provide feedback related to the content on this product.
Product Title
Spot an opportunity for improvement?Share a Content Correction